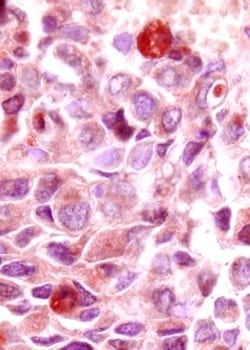

AB29397
26172-81-6 | 1-Anthracenecarboxylic acid, 9,10-dihydro-9-oxo-
Manufacturer: A2B Chem
CAS Number: 26172-81-6
The price for this product is unavailable. Please request a quote
Catalog Number
AB29397
Chemical Name
1-Anthracenecarboxylic acid, 9,10-dihydro-9-oxo-
Cas Number
26172-81-6
Molecular Formula
C15H10O3
Molecular Weight
238.2381
Mdl Number
MFCD00604746
Smiles
OC(=O)c1cccc2c1C(=O)c1c(C2)cccc1